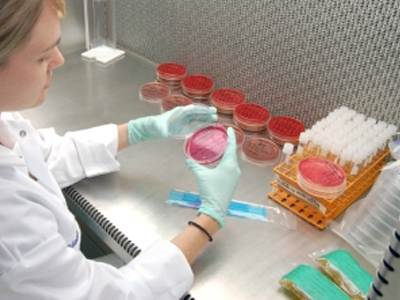
Στη… φάκα μικροβιολόγος που απέφυγε τον φορολογικό έλεγχο

Μικροβιολόγος: Με «κόλπα» έβγαλαν Covid free την Κάρπαθο – Σοβαρές καταγγελίες στο zougla.gr
Είναι δυνατόν ένα ολόκληρο νησί στα Δωδεκάνησα εν μέσω της καλοκαιρινής τουριστικής περιόδου να βγαίνει Covid free, να μην υπάρχει δηλαδή ούτε ένα θετικό rapid test, ανάμεσα στα παραπάνω από 65.000 δείγματα...
09/02/2022 | 16:51